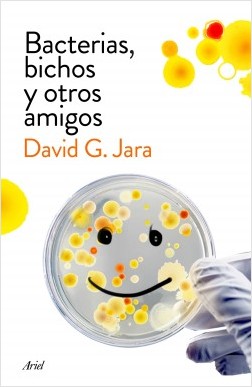

Los secretos de flora
historias mínimas de plantas, moléculas y humanos
- ISBN: 9788434437272
- Editorial: Editorial Ariel
- Fecha de la edición: 2024
- Lugar de la edición: Barcelona. España
- Encuadernación: Cartoné
- Medidas: 24 cm
- Nº Pág.: 296
- Idiomas: Español

Historias humanas y hallazgos científicos que dan una visión completa del complejo mundo químico que atesoran las plantas.
No existe nada tan falaz como la mansedumbre de una planta. Acostumbrados a su liviana y silenciosa compañía, narcotizados por los colores y los aromas que gritan sus flores, en pocas ocasiones somos conscientes de que estamos ante los más expertos alquimistas de la naturaleza. El mundo vegetal oculta prodigiosas sustancias que pueden mitigar el dolor y el sufrimiento humano, capaces de curar enfermedades y, a la vez, arrancarnos la vida en un suspiro. Una planta puso fin a la existencia del mejor de los hombres; otra acompañó a Marco Aurelio durante sus largas meditaciones; y Freud creyó encontrar una sustancia milagrosa en la misma planta que a muchos otros ha conducido a la muerte.
En las páginas de este libro recurriremos a la ciencia, la historia y la antropología para desvelar muchos de los secretos, algunos ya revelados y otros todavía por descubrir, que esconden las plantas bajo su bella e inofensiva apariencia. Secretos cuya naturaleza química es capaz de provocarnos las más potentes adicciones, esconder los fármacos más prometedores e imaginar los más letales venenos.